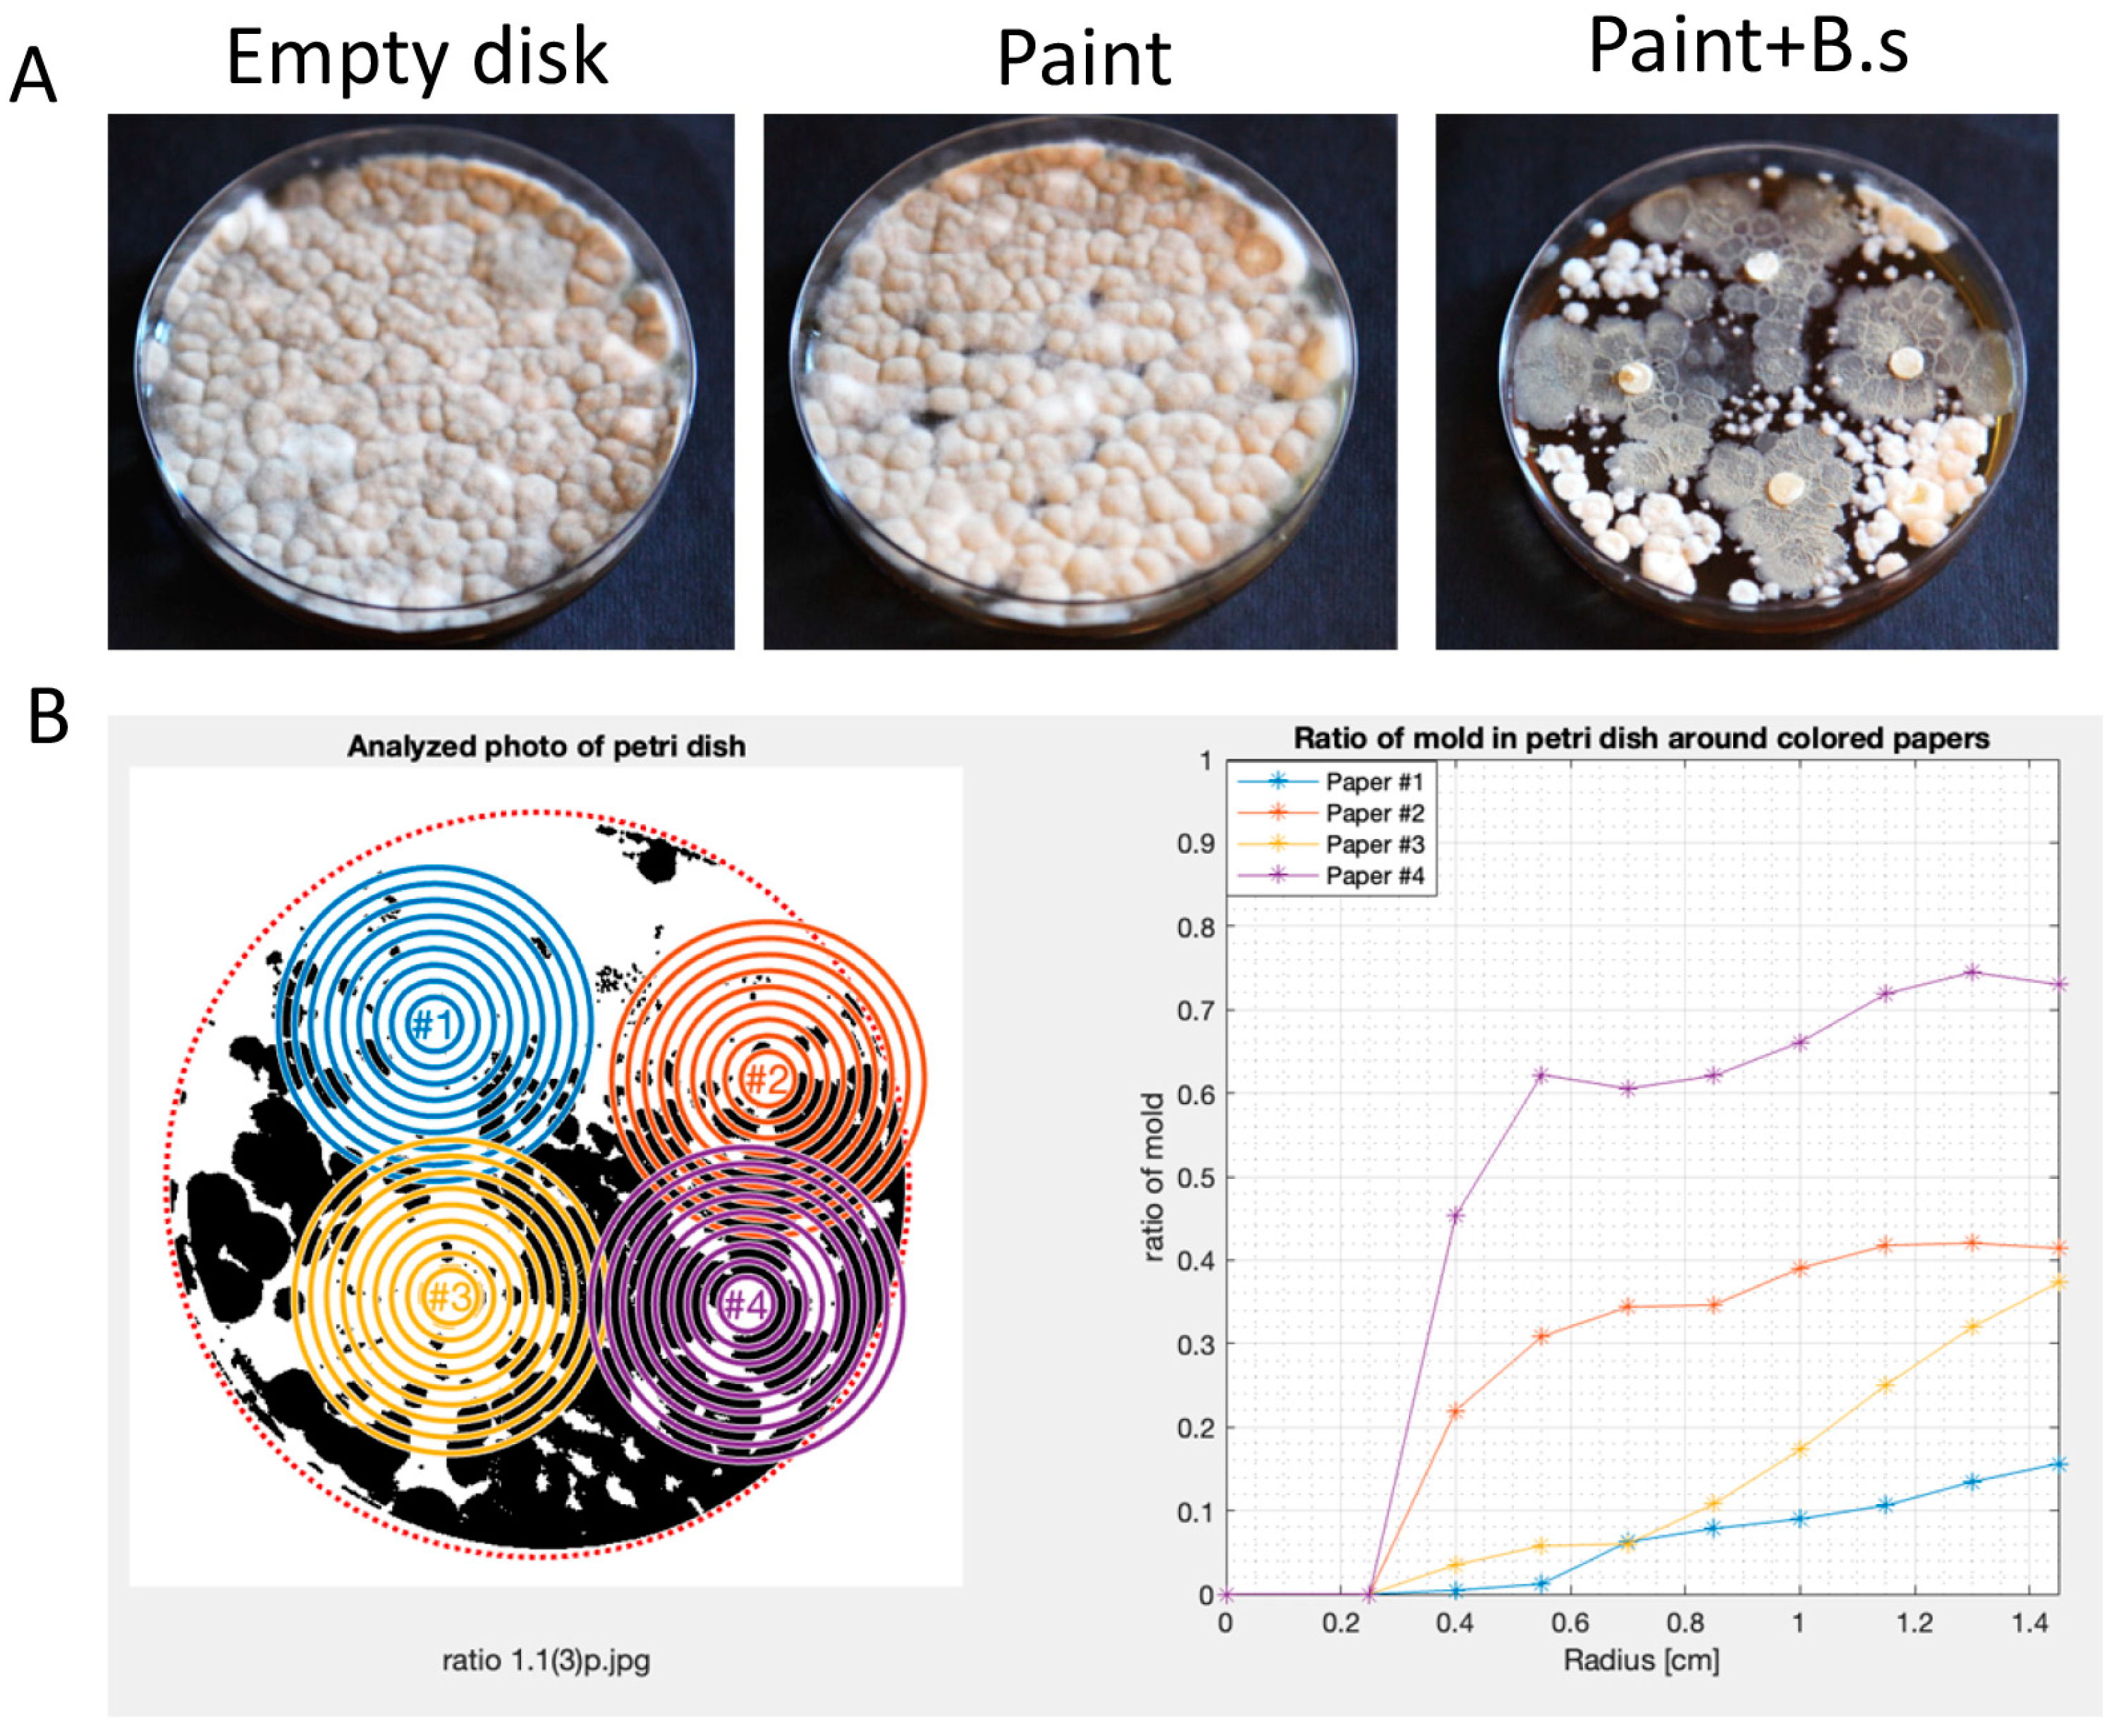
Microorganisms 12 01226 g003

The Utilization of Bacillus subtilis to Design Environmentally Friendly Living Paints with Anti-Mold Properties
Abstract
1. Introduction
2. Materials and Methods
3. Results
3.1. Antifungal Effects Are Achieved Using Multiple Biosynthetic Clusters
3.2. Bacillus subtilis Can Robustly Enhance the Anti-Mold Properties of Commercial Paints
3.3. Bacillus subtilis Can Survive as a Viable Agent and Sporulate in Paint Preparative
4. Discussion
Supplementary Materials
Author Contributions
Funding
Data Availability Statement
Conflicts of Interest
References
- Rudrappa, T.; Biedrzycki, M.L.; Kunjeti, S.G.; Donofrio, N.M.; Czymmek, K.J.; Pare, P.W.; Bais, H.P. The rhizobacterial elicitor acetoin induces systemic resistance in Arabidopsis thaliana. Commun. Integr. Biol. 2010, 3, 130–138. [Google Scholar] [CrossRef]
- Beys-da-Silva, W.O.; Santi, L.; Berger, M.; Calzolari, D.; Passos, D.O.; Guimaraes, J.A.; Moresco, J.J.; Yates, J.R. Secretome of the biocontrol agent metarhizium anisopliae induced by the cuticle of the cotton pest Dysdercus peruvianus reveals new insights into infection. J. Proteome Res. 2014, 13, 2282–2296. [Google Scholar] [CrossRef]
- Frost, I.; Smith, W.P.J.; Mitri, S.; Millan, A.S.; Davit, Y.; Osborne, J.M.; Pitt-Francis, J.M.; MacLean, R.C.; Foster, K.R. Cooperation, competition and antibiotic resistance in bacterial colonies. ISME J. 2018, 12, 1582–1593. [Google Scholar] [CrossRef]
- Niehus, R.; Mitri, S. Handling unpredictable ecosystems. Nat. Ecol. Evol. 2018, 2, 1207–1208. [Google Scholar] [CrossRef]
- Zhu, H.; Sandiford, S.K.; van Wezel, G.P. Triggers and cues that activate antibiotic production by actinomycetes. J. Ind. Microbiol. Biotechnol. 2014, 41, 371–386. [Google Scholar] [CrossRef]
- Arakawa, K. Manipulation of metabolic pathways controlled by signaling molecules, inducers of antibiotic production, for genome mining in Streptomyces spp. Antonie Van Leeuwenhoek 2018, 111, 743–751. [Google Scholar] [CrossRef]
- Cornforth, D.M.; Foster, K.R. Competition sensing: The social side of bacterial stress responses. Nat. Rev. Microbiol. 2013, 11, 285–293. [Google Scholar] [CrossRef]
- Hou, Q.; Kolodkin-Gal, I. Harvesting the complex pathways of antibiotic production and resistance of soil bacilli for optimizing plant microbiome. FEMS Microbiol. Ecol. 2020, 96, fiaa142. [Google Scholar] [CrossRef]
- Hou, Q.; Keren-Paz, A.; Korenblum, E.; Oved, R.; Malitsky, S.; Kolodkin-Gal, I. Weaponizing volatiles to inhibit competitor biofilms from a distance. NPJ Biofilms Microbiomes 2021, 7, 2. [Google Scholar] [CrossRef] [PubMed]
- Shank, E.A. Considering the Lives of Microbes in Microbial Communities. mSystems 2018, 3, 00155-17. [Google Scholar] [CrossRef] [PubMed]
- Shank, E.A.; Klepac-Ceraj, V.; Collado-Torres, L.; Powers, G.E.; Losick, R.; Kolter, R. Interspecies interactions that result in Bacillus subtilis forming biofilms are mediated mainly by members of its own genus. Proc. Natl. Acad. Sci. USA 2011, 108, E1236–E1243. [Google Scholar] [CrossRef] [PubMed]
- Lyons, N.A.; Kraigher, B.; Stefanic, P.; Mandic-Mulec, I.; Kolter, R. A Combinatorial Kin Discrimination System in Bacillus subtilis. Curr. Biol. 2016, 26, 733–742. [Google Scholar] [CrossRef] [PubMed]
- Stefanic, P.; Kraigher, B.; Lyons, N.A.; Kolter, R.; Mandic-Mulec, I. Kin discrimination between sympatric Bacillus subtilis isolates. Proc. Natl. Acad. Sci. USA 2015, 112, 14042–14047. [Google Scholar] [CrossRef] [PubMed]
- Kalamara, M.; Spacapan, M.; Mandic-Mulec, I.; Stanley-Wall, N.R. Social behaviours by Bacillus subtilis: Quorum sensing, kin discrimination and beyond. Mol. Microbiol. 2018, 110, 863–878. [Google Scholar] [CrossRef] [PubMed]
- Harris, K.D.; Kolodkin-Gal, I. Applying the handicap principle to biofilms: Condition-dependent signalling in Bacillus subtilis microbial communities. Environ. Microbiol. 2018, 21, 531–540. [Google Scholar] [CrossRef] [PubMed]
- Dorrestein, P.C.; Kelleher, N.L. Dissecting non-ribosomal and polyketide biosynthetic machineries using electrospray ionization Fourier-Transform mass spectrometry. Nat. Prod. Rep. 2006, 23, 893–918. [Google Scholar] [CrossRef] [PubMed]
- Bloudoff, K.; Schmeing, T.M. Structural and functional aspects of the nonribosomal peptide synthetase condensation domain superfamily: Discovery, dissection and diversity. Biochim. Biophys. Acta Proteins Proteom. 2017, 1865, 1587–1604. [Google Scholar] [CrossRef]
- Bais, H.P.; Fall, R.; Vivanco, J.M. Biocontrol of Bacillus subtilis against infection of Arabidopsis roots by Pseudomonas syringae is facilitated by biofilm formation and surfactin production. Plant Physiol. 2004, 134, 307–319. [Google Scholar] [CrossRef] [PubMed]
- Chen, Y.; Yan, F.; Chai, Y.; Liu, H.; Kolter, R.; Losick, R.; Guo, J.H. Biocontrol of tomato wilt disease by Bacillus subtilis isolates from natural environments depends on conserved genes mediating biofilm formation. Environ. Microbiol. 2013, 15, 848–864. [Google Scholar] [CrossRef]
- Butcher, R.A.; Schroeder, F.C.; Fischbach, M.A.; Straight, P.D.; Kolter, R.; Walsh, C.T.; Clardy, J. The identification of bacillaene, the product of the PksX megacomplex in Bacillus subtilis. Proc. Natl. Acad. Sci. USA 2007, 104, 1506–1509. [Google Scholar] [CrossRef]
- Tsuge, K.; Ano, T.; Shoda, M. Isolation of a gene essential for biosynthesis of the lipopeptide antibiotics plipastatin B1 and surfactin in Bacillus subtilis YB8. Arch. Microbiol. 1996, 165, 243–251. [Google Scholar] [CrossRef] [PubMed]
- Coutte, F.; Leclere, V.; Bechet, M.; Guez, J.S.; Lecouturier, D.; Chollet-Imbert, M.; Dhulster, P.; Jacques, P. Effect of pps disruption and constitutive expression of srfA on surfactin productivity, spreading and antagonistic properties of Bacillus subtilis 168 derivatives. J. Appl. Microbiol. 2010, 109, 480–491. [Google Scholar] [CrossRef]
- Hilton, M.D.; Alaeddinoglu, N.G.; Demain, A.L. Synthesis of bacilysin by Bacillus subtilis branches from prephenate of the aromatic amino acid pathway. J. Bacteriol. 1988, 170, 482–484. [Google Scholar] [CrossRef]
- Maan, H.; Itkin, M.; Malitsky, S.; Friedman, J.; Kolodkin-Gal, I. Resolving the conflict between antibiotic production and rapid growth by recognition of peptidoglycan of susceptible competitors. Nat. Commun. 2022, 13, 431. [Google Scholar] [CrossRef]
- Magnuson, R.; Solomon, J.; Grossman, A.D. Biochemical and genetic characterization of a competence pheromone from B. subtilis. Cell 1994, 77, 207–216. [Google Scholar] [CrossRef] [PubMed]
- Nakano, M.M.; Magnuson, R.; Myers, A.; Curry, J.; Grossman, A.D.; Zuber, P. Srfa Is an Operon Required for Surfactin Production, Competence Development, and Efficient Sporulation in Bacillus subtilis. J. Bacteriol. 1991, 173, 1770–1778. [Google Scholar] [CrossRef]
- Danevcic, T.; Dragos, A.; Spacapan, M.; Stefanic, P.; Dogsa, I.; Mandic-Mulec, I. Surfactin Facilitates Horizontal Gene Transfer in Bacillus subtilis. Front. Microbiol. 2021, 12, 657407. [Google Scholar] [CrossRef] [PubMed]
- Kluge, B.; Vater, J.; Salnikow, J.; Eckart, K. Studies on the Biosynthesis of Surfactin, a Lipopeptide Antibiotic from Bacillus-subtilis Atcc-21332. FEBS Lett. 1988, 231, 107–110. [Google Scholar] [CrossRef]
- Gonzalez, D.J.; Haste, N.M.; Hollands, A.; Fleming, T.C.; Hamby, M.; Pogliano, K.; Nizet, V.; Dorrestein, P.C. Microbial competition between Bacillus subtilis and Staphylococcus aureus monitored by imaging mass spectrometry. Microbiology 2011, 157, 2485–2492. [Google Scholar] [CrossRef]
- Rosenberg, G.; Steinberg, N.; Oppenheimer-Shaanan, Y.; Olender, T.; Doron, S.; Ben-Ari, J.; Sirota-Madi, A.; Bloom-Ackermann, Z.; Kolodkin-Gal, I. Not so simple, not so subtle: The interspecies competition between Bacillus simplex and Bacillus subtilis and its impact on the evolution of biofilms. NPJ Biofilms Microbiomes 2016, 2, 15027. [Google Scholar] [CrossRef]
- Falardeau, J.; Wise, C.; Novitsky, L.; Avis, T.J. Ecological and mechanistic insights into the direct and indirect antimicrobial properties of Bacillus subtilis lipopeptides on plant pathogens. J. Chem. Ecol. 2013, 39, 869–878. [Google Scholar] [CrossRef] [PubMed]
- Straight, P.D.; Fischbach, M.A.; Walsh, C.T.; Rudner, D.Z.; Kolter, R. A singular enzymatic megacomplex from Bacillus subtilis. Proc. Natl. Acad. Sci. USA 2007, 104, 305–310. [Google Scholar] [CrossRef]
- Rajavel, M.; Mitra, A.; Gopal, B. Role of Bacillus subtilis BacB in the synthesis of bacilysin. J. Biol. Chem. 2009, 284, 31882–31892. [Google Scholar] [CrossRef] [PubMed]
- Chen, X.H.; Scholz, R.; Borriss, M.; Junge, H.; Mogel, G.; Kunz, S.; Borriss, R. Difficidin and bacilysin produced by plant-associated Bacillus amyloliquefaciens are efficient in controlling fire blight disease. J. Biotechnol. 2009, 140, 38–44. [Google Scholar] [CrossRef] [PubMed]
- Wu, L.M.; Wu, H.J.; Chen, L.; Yu, X.F.; Borriss, R.; Gao, X.W. Difficidin and bacilysin from Bacillus amyloliquefaciens FZB42 have antibacterial activity against Xanthomonas oryzae rice pathogens. Sci. Rep. 2015, 5, 12975. [Google Scholar] [CrossRef] [PubMed]
- Hanif, A.; Zhang, F.; Li, P.; Li, C.; Xu, Y.; Zubair, M.; Zhang, M.; Jia, D.; Zhao, X.; Liang, J.; et al. Fengycin Produced by Bacillus amyloliquefaciens FZB42 Inhibits Fusarium graminearum Growth and Mycotoxins Biosynthesis. Toxins 2019, 11, 295. [Google Scholar] [CrossRef] [PubMed]
- Li, Y.; Heloir, M.C.; Zhang, X.; Geissler, M.; Trouvelot, S.; Jacquens, L.; Henkel, M.; Su, X.; Fang, X.; Wang, Q.; et al. Surfactin and fengycin contribute to the protection of a Bacillus subtilis strain against grape downy mildew by both direct effect and defence stimulation. Mol. Plant Pathol. 2019, 20, 1037–1050. [Google Scholar] [CrossRef] [PubMed]
- Hamley, I.W.; Dehsorkhi, A.; Jauregi, P.; Seitsonen, J.; Ruokolainen, J.; Coutte, F.; Chataigne, G.; Jacques, P. Self-assembly of three bacterially-derived bioactive lipopeptides. Soft Matter 2013, 9, 9572–9578. [Google Scholar] [CrossRef]
- Wang, T.; Liu, X.H.; Wu, M.B.; Ge, S. Molecular insights into the antifungal mechanism of bacilysin. J. Mol. Model. 2018, 24, 118. [Google Scholar] [CrossRef]
- Tran, C.; Cock, I.E.; Chen, X.; Feng, Y. Antimicrobial Bacillus: Metabolites and Their Mode of Action. Antibiotics 2022, 11, 88. [Google Scholar] [CrossRef]
- Pettigrew, H.D.; Selmi, C.F.; Teuber, S.S.; Gershwin, M.E. Mold and human health: Separating the wheat from the chaff. Clin. Rev. Allergy Immunol. 2010, 38, 148–155. [Google Scholar] [CrossRef] [PubMed]
- Zuo, R.; Wood, T.K. Inhibiting mild steel corrosion from sulfate-reducing and iron-oxidizing bacteria using gramicidin-S-producing biofilms. Appl. Microbiol. Biotechnol. 2004, 65, 747–753. [Google Scholar] [CrossRef] [PubMed]
- Suissa, R.; Oved, R.; Jankelowitz, G.; Turjeman, S.; Koren, O.; Kolodkin-Gal, I. Molecular genetics for probiotic engineering: Dissecting lactic acid bacteria. Trends Microbiol. 2022, 30, 293–306. [Google Scholar] [CrossRef] [PubMed]
- Branda, S.S.; Gonzalez-Pastor, J.E.; Ben-Yehuda, S.; Losick, R.; Kolter, R. Fruiting body formation by Bacillus subtilis. Proc. Natl. Acad. Sci. USA 2001, 98, 11621–11626. [Google Scholar] [CrossRef] [PubMed]
- Keren-Paz, A.; Brumfeld, V.; Oppenheimer-Shaanan, Y.; Kolodkin-Gal, I. Micro-CT X-ray imaging exposes structured diffusion barriers within biofilms. NPJ Biofilms Microbiomes 2018, 4, 8. [Google Scholar] [CrossRef] [PubMed]
- Oppenheimer-Shaanan, Y.; Sibony-Nevo, O.; Bloom-Ackermann, Z.; Suissa, R.; Steinberg, N.; Kartvelishvily, E.; Brumfeld, V.; Kolodkin-Gal, I. Spatio-temporal assembly of functional mineral scaffolds within microbial biofilms. NPJ Biofilms Microbiomes 2016, 2, 15031. [Google Scholar] [CrossRef]
- Bucher, T.; Kartvelishvily, E.; Kolodkin-Gal, I. Methodologies for Studying B. subtilis Biofilms as a Model for Characterizing Small Molecule Biofilm Inhibitors. J. Vis. Exp. 2016, 116, 54612. [Google Scholar] [CrossRef] [PubMed]
- Suissa, R.; Oved, R.; Maan, H.; Hadad, U.; Gilhar, O.; Meijler, M.M.; Koren, O.; Kolodkin-Gal, I. Context-dependent differences in the functional responses of Lactobacillaceae strains to fermentable sugars. Front. Microbiol. 2022, 13, 949932. [Google Scholar] [CrossRef] [PubMed]
- Vitale, R.G.; Mouton, J.W.; Afeltra, J.; Meis, J.F.; Verweij, P.E. Method for measuring postantifungal effect in Aspergillus species. Antimicrob. Agents Chemother. 2002, 46, 1960–1965. [Google Scholar] [CrossRef]
- Miyazawa, K.; Umeyama, T.; Hoshino, Y.; Abe, K.; Miyazaki, Y. Quantitative Monitoring of Mycelial Growth of Aspergillus fumigatus in Liquid Culture by Optical Density. Microbiol. Spectr. 2022, 10, e0006321. [Google Scholar] [CrossRef]
- Branda, S.S.; Gonzalez-Pastor, J.E.; Dervyn, E.; Ehrlich, S.D.; Losick, R.; Kolter, R. Genes involved in formation of structured multicellular communities by Bacillus subtilis. J. Bacteriol. 2004, 186, 3970–3979. [Google Scholar] [CrossRef] [PubMed]
- Barak, I.; Ricca, E.; Cutting, S.M. From fundamental studies of sporulation to applied spore research. Mol. Microbiol. 2005, 55, 330–338. [Google Scholar] [CrossRef] [PubMed]
- Vahidinasab, M.; Lilge, L.; Reinfurt, A.; Pfannstiel, J.; Henkel, M.; Morabbi Heravi, K.; Hausmann, R. Construction and description of a constitutive plipastatin mono-producing Bacillus subtilis. Microb. Cell Fact. 2020, 19, 205. [Google Scholar] [CrossRef] [PubMed]
- Dorfan, Y.; Yael, M.; Shohat, B.; Kolodkin-Gal, I. Sustainable construction: Toward growing biocement with synthetic biology. Res. Dir. Biotechnol. Des. 2023, 1, e14. [Google Scholar] [CrossRef]
- Su, Y.; Liu, C.; Fang, H.; Zhang, D. Bacillus subtilis: A universal cell factory for industry, agriculture, biomaterials and medicine. Microb. Cell Fact. 2020, 19, 173. [Google Scholar] [CrossRef] [PubMed]
- Benoit, I.; van den Esker, M.H.; Patyshakuliyeva, A.; Mattern, D.J.; Blei, F.; Zhou, M.; Dijksterhuis, J.; Brakhage, A.A.; Kuipers, O.P.; de Vries, R.P.; et al. Bacillus subtilis attachment to Aspergillus niger hyphae results in mutually altered metabolism. Environ. Microbiol. 2015, 17, 2099–2113. [Google Scholar] [CrossRef] [PubMed]
- Siahmoshteh, F.; Siciliano, I.; Banani, H.; Hamidi-Esfahani, Z.; Razzaghi-Abyaneh, M.; Gullino, M.L.; Spadaro, D. Efficacy of Bacillus subtilis and Bacillus amyloliquefaciens in the control of Aspergillus parasiticus growth and aflatoxins production on pistachio. Int. J. Food Microbiol. 2017, 254, 47–53. [Google Scholar] [CrossRef] [PubMed]
- Ogran, A.; Yardeni, E.H.; Keren-Paz, A.; Bucher, T.; Jain, R.; Gilhar, O.; Kolodkin-Gal, I. The Plant Host Induces Antibiotic Production To Select the Most-Beneficial Colonizers. Appl. Environ. Microbiol. 2019, 85, e00512-19. [Google Scholar] [CrossRef] [PubMed]
- Arnaouteli, S.; Bamford, N.C.; Stanley-Wall, N.R.; Kovacs, A.T. Bacillus subtilis biofilm formation and social interactions. Nat. Rev. Microbiol. 2021, 19, 600–614. [Google Scholar] [CrossRef]
- Hassanov, T.; Karunker, I.; Steinberg, N.; Erez, A.; Kolodkin-Gal, I. Novel antibiofilm chemotherapies target nitrogen from glutamate and glutamine. Sci. Rep. 2018, 8, 7097. [Google Scholar] [CrossRef]
- Shemesh, M.; Chai, Y. A combination of glycerol and manganese promotes biofilm formation in Bacillus subtilis via histidine kinase KinD signaling. J. Bacteriol. 2013, 195, 2747–2754. [Google Scholar] [CrossRef] [PubMed]
- Wassermann, B.; Abdelfattah, A.; Cernava, T.; Wicaksono, W.; Berg, G. Microbiome-based biotechnology for reducing food loss post harvest. Curr. Opin. Biotechnol. 2022, 78, 102808. [Google Scholar] [CrossRef] [PubMed]
- Wozniak, M. Antifungal Agents in Wood Protection-A Review. Molecules 2022, 27, 6392. [Google Scholar] [CrossRef] [PubMed]
- Ulrich, N.; Nagler, K.; Laue, M.; Cockell, C.S.; Setlow, P.; Moeller, R. Experimental studies addressing the longevity of Bacillus subtilis spores—The first data from a 500-year experiment. PLoS ONE 2018, 13, e0208425. [Google Scholar] [CrossRef]
- Maan, H.; Gilhar, O.; Porat, Z.; Kolodkin-Gal, I. Bacillus subtilis Colonization of Arabidopsis thaliana Roots Induces Multiple Biosynthetic Clusters for Antibiotic Production. Front. Cell. Infect. Microbiol. 2021, 11, 722778. [Google Scholar] [CrossRef]
- Timmis, K.; de Vos, W.M.; Ramos, J.L.; Vlaeminck, S.E.; Prieto, A.; Danchin, A.; Verstraete, W.; de Lorenzo, V.; Lee, S.Y.; Brussow, H.; et al. The contribution of microbial biotechnology to sustainable development goals. Microb. Biotechnol. 2017, 10, 984–987. [Google Scholar] [CrossRef] [PubMed]

Disclaimer/Publisher’s Note: The statements, opinions and data contained in all publications are solely those of the individual author(s) and contributor(s) and not of MDPI and/or the editor(s). MDPI and/or the editor(s) disclaim responsibility for any injury to people or property resulting from any ideas, methods, instructions or products referred to in the content. |
© 2024 by the authors. Licensee MDPI, Basel, Switzerland. This article is an open access article distributed under the terms and conditions of the Creative Commons Attribution (CC BY) license (https://creativecommons.org/licenses/by/4.0/).
Share and Cite
Dorfan, Y.; Nahami, A.; Morris, Y.; Shohat, B.; Kolodkin-Gal, I. The Utilization of Bacillus subtilis to Design Environmentally Friendly Living Paints with Anti-Mold Properties. Microorganisms 2024, 12, 1226. https://doi.org/10.3390/microorganisms12061226
Dorfan Y, Nahami A, Morris Y, Shohat B, Kolodkin-Gal I. The Utilization of Bacillus subtilis to Design Environmentally Friendly Living Paints with Anti-Mold Properties. Microorganisms. 2024; 12(6):1226. https://doi.org/10.3390/microorganisms12061226
Chicago/Turabian StyleDorfan, Yuval, Avichay Nahami, Yael Morris, Benny Shohat, and Ilana Kolodkin-Gal. 2024. "The Utilization of Bacillus subtilis to Design Environmentally Friendly Living Paints with Anti-Mold Properties" Microorganisms 12, no. 6: 1226. https://doi.org/10.3390/microorganisms12061226
APA StyleDorfan, Y., Nahami, A., Morris, Y., Shohat, B., & Kolodkin-Gal, I. (2024). The Utilization of Bacillus subtilis to Design Environmentally Friendly Living Paints with Anti-Mold Properties. Microorganisms, 12(6), 1226. https://doi.org/10.3390/microorganisms12061226

